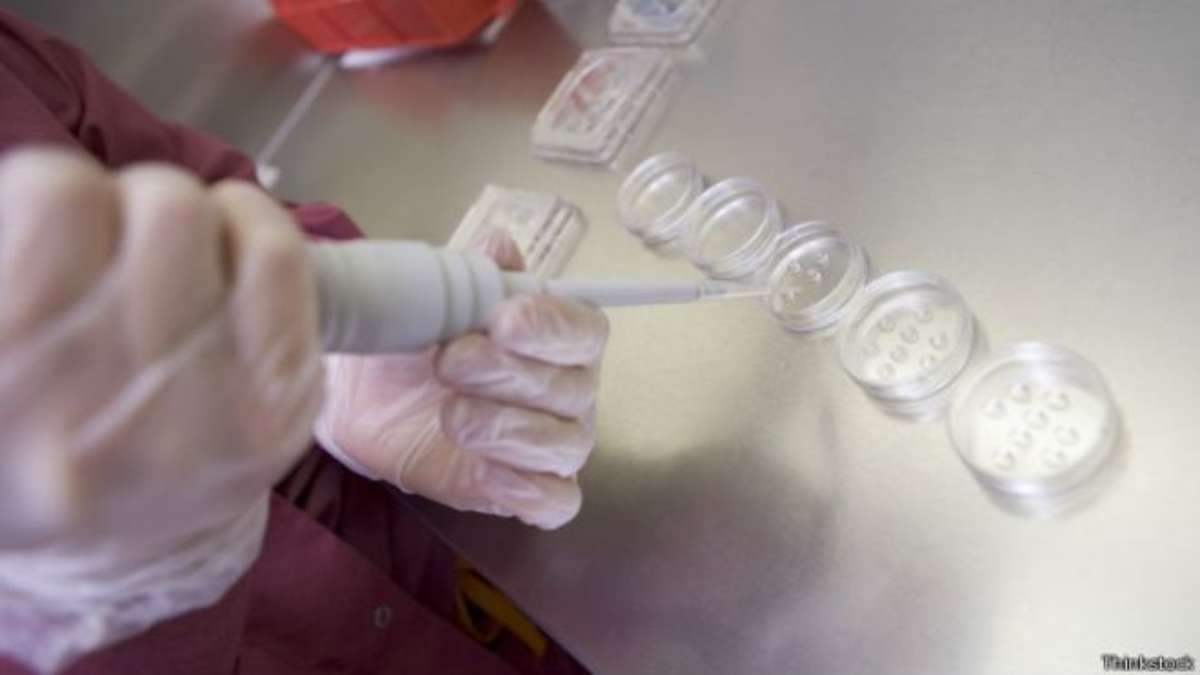

esperma bom

β‘ ππ»ππ»ππ» FOR MORE INFORMATION, CLICK HERE ππ»ππ»ππ»
Free Web Cam Girls Live
Teens Having Sex In Public
French Teen Suck a Dick
Senior girls spank mags
Humongous cleavage of the mature lady
Hentai Planet Sheen Porn
redchasten non-professional record 07/04/15 on twenty one:52 from MyFreecams
esperma bom




































resize:640x">quality:90x75/images/17467f4a2ad97e585e71cefce01c881faf7af09227d457d21f6506ead5849c4c_1.jpg">